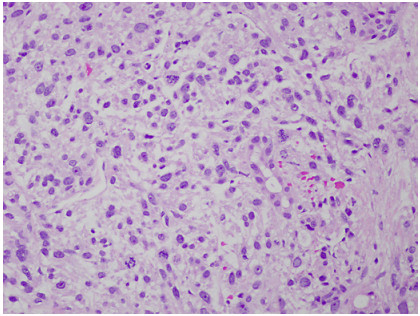

-
About this article
Cite this article
Karim Abou El Joud, Misha Abbasi. 2022. Lower Extremity Varicose Veins: An Unusual Presentation of Small Bowel Leiomyosarcoma. Gastrointestinal Tumors. 9:2 doi: 10.1159/000520802
Lower Extremity Varicose Veins: An Unusual Presentation of Small Bowel Leiomyosarcoma
- Received: 25 January 2021
- Accepted: 08 November 2021
- Published online: 18 November 2021
Abstract: Leiomyosarcomas (LMSs) are extremely rare and comprise only 1.2% of small bowel malignancies. Advancements in immunohistochemical techniques have allowed for the differentiation between LMSs and gastrointestinal stromal tumors. LMSs remain difficult to detect via endoscopy and require a more intricate diagnostic approach. The staging and sizing of these tumors are important prognostic indicators. We report a case of a 67-year-old male who presented with bulging lower extremity veins, abdominal bloating, and weight loss. A CT of the abdomen and pelvis revealed a pelvic mass arising from the small bowel and a metastatic hepatic lesion, which was found to be compressing the inferior vena cava. A biopsy of the hepatic lesion confirmed the diagnosis of metastatic LMS.
-
Key words:
- Leiomyosarcoma /
- Small intestine /
- Gastrointestinal stromal tumor /
- Stromal tumors